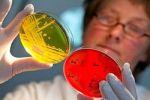
Учеными установлена связь между кишечной инфекцией и шизофренией

Архив новостей 10 апреля 2013 г.

Запретные женские радости (2005) SATRip
Хотелось бы вам узнать о женских ощущениях при половом акте? Или о том, что же на самом деле доводит женщину до оргазма? После проведённых серьёзных...

В краевом центре 13 апреля пройдет «Гагаринская зарядка»
13 апреля в 10:00 на площади им. Ленина города Ставрополя состоится массовое и зрелищное спортивное мероприятие – «Гагаринская зарядка», сообщает крае...

Сборная Ставрополья блестяще выступила на первенстве России по рукопашному бою
Более пятисот юношей и девушек в возрасте от 14 до 17 лет из 40 регионов оспаривали в Астрахани награды первенства России по рукопашному бою...

Уставной капитал международного аэропорта «Ставрополь» будет увеличен на 7,3 миллиона рублей
Министерство имущественных отношений Ставропольского края в 2013 году займется направлением бюджетных инвестиций в ОАО «Международный аэропорт Ставроп...

Туристический потенциал Ставрополя заинтересовал участников Международного фестиваля «Мир без границ»
В Ростове-на-Дону прошел XVI Международный фестиваль туризма «Мир без границ». В нем приняла участие делегация города Ставрополя, сообщила пресс-служб...

Рынок страхования АПК на Ставрополье стал одним из наиболее развитых в стране
В краевом министерстве экономического развития под руководством заместителя председателя правительства Ставрополья Андрея Бурзака состоялось заседание...

Ставрополец стал двукратным призером чемпионата России по настольному теннису
В городе Алексин Тульской области прошел чемпионат России по настольному теннису среди спортсменов с поражением опорно-двигательного аппарата...

Ставропольские спасатели - лучшие в СКФО по оказанию помощи в ДТП
На Ставрополье прошли соревнования на звание «Лучшая команда Северо-Кавказского регионального центра МЧС России по проведению аварийно-спасательных ра...

У Даны Борисовой похитили миллион
Известная российская телеведущая Дана Борисова угодила в неприятную ситуацию - он оказалась обманута собственным директором. Отечественная теледива в...

На Ставрополье сотрудники полиции задержали мошенницу, находившуюся в федеральном розыске
Полицейские Шпаковского района задержали женщину, с 2010 года находившуюся в федеральном розыске. Жительница Ставропольского края неоднократно привлек...

Джастин Тимберлейк пытается избавиться от вредной привычки
Известный актер и певец Джастин Тимберлейк изо всех сил пытается избавиться от вредной привычки – он хочет бросить курить. Он хочет в ближайшем будуще...

Кэти Холмс нашла новую любовь
В жизни голливудской актрисы Кэти Холмс появился новый мужчина. В прошлом году знаменитость подала на развод с Томом Крузом, что стало шоком для общес...

Более 200 нарушений миграционного законодательства выявлено на Ставрополье
УФМС России по Ставропольскому краю проведены два оперативно-профилактических мероприятия по выявлению нарушителей миграционного законодательства, соо...

Отец Майли Сайрус – против свадьбы
Отец популярной певицы и актрисы Майли Сайрус Билли Рэй Сайрус не хочет, чтобы она вышла замужза Лиама Хемсворта. Как только его дочь сообщила о помол...

Хизер Моррис ждет ребенка
Звезда американского сериала «Хор» Хизер Моррис готовится стать мамой. Это – первый ребенок 26-летней Хизер и ее давнего возлюбленного Тейлора Хаббелл...

Том Круз верит в инопланетян
Голливудский актер Том Круз признался, что верит в инопланетян, и что он даже хотел бы покинуть Землю и отправиться в путешествие, чтобы встретиться с...

В этом году 11 ветеранов из Ставрополя получили квартиры
В администрации города был поднят вопрос обеспечения ветеранов жильем, сообщает пресс-служба мэрии. В ходе заседания было отмечено, что с начала этого...

Кристен Стюарт мечтает о прибавлении в семействе
Звезда «Сумеречной саги» Кристен Стюарт призналась, что у нее есть тайная мечта. Актриса очень хотела, чтобы ее возлюбленный Роберт Паттинсон подарил...

Анджелина Джоли тайно встречается с бывшим мужем
Одна из самых популярных голливудских актрис Анджелина Джоли, которая воспитывает шестерых детей со своим возлюбленным Брэдом Питтом, устраивает секре...

Пожизненный срок получил педофил и убийца из Пятигорска Владимир Амбарцумов
Сегодня, 10 апреля, завершились слушания по уголовному делу в отношении Владимира Амбарцумова. Он признан виновным в насильственных действиях сексуаль...

Брэдли Купер получил любовные советы от Леонардо ДиКаприо
Брэдли Купер, сердце которого до сих пор свободно, получил несколько советов относительно любви и свиданий от своего коллеги Леонардо ДиКаприо...

Джессика Симпсон, наконец, определилась с датой свадьбы
Джессика Симпсон, которая в настоящее время ждет своего второго ребенка, определилась с датой предстоящей свадьбы. Певица вынуждена была отменить свад...

Дрю Бэрримор рассказала о своих жертвах
Известная актриса Дрю Бэрримор решила рассказать о том, как изменилась ее жизнь из-за материнства. Знаменитость призналась, что ей пришлось многим пож...

Делегация Ставрополья приняла участие в Международной выставке в Баку
Делегация Ставропольского края приняла участие в работе Азербайджанской Международной выставки «Туризм и Путешествия» AITF-2013 и 7-й Кавказской Между...
Учеными установлена связь между кишечной инфекцией и шизофренией
В австралийском Кертенском технологическом институте учеными была установлена связь между шизофренией и пищеварительной инфекцией...

Люди, сделавшие пластическую операцию, чувствуют себя счастливее
Совсем недавно психологи утверждали, что негативными последствиями пластических операций являются депрессии, психические расстройства и в отдельных сл...

Более семи тысяч школьников из Ставрополя отдохнут в городских летних лагерях
Во время летних каникул в Ставрополе будут работать более сорока оздоровительных лагерей, которые примут 7,6 тысячи школьников, сообщила пресс-служба...

В Михайловске погиб рабочий, упав в шахту для слива бетона
В Шпаковском районе проводится доследственная проверка по факту смерти мужчины на производстве. Об этом сообщила в среду помощник руководителя следств...

Хлое Кардашян готовится стать мамой
Одна из сестер Кардашян Хлое отчаянно пытается завести ребенка. Звезда шоу-бизнеса была поражена, когда ее сестра Ким сообщила о своей беременности. Х...

К 9 Мая в Ставрополе зацветут 190 тысяч тюльпанов
В преддверии Дня Победы на клумбах в центральной части города и на въездах в Ставрополь будут высажены весенние цветущие композиции, в которых будет и...

Суд обязал комитет городского хозяйства администрации Ставрополя установить ограждение на ул. Лермонтова
Прокуратура Ленинского района Ставрополя провела проверку по обращениям граждан о неисполнении требований законодательства в области обеспечения безоп...

Проект «Вузы родному городу» поможет школьникам Ставрополя определиться с будущей профессией
Летом школьникам помогут определиться с будущей профессией. Впервые в этом году, во время школьных летних каникул, администрация города Ставрополя сов...

Как влияет мед на наш организм?
Итак, поговорим немного о мёде. Еще в давнее время, греки использовали мёд в разных применениях: давали воинам в походи в их паек, лечили больных, зас...

Видео с пьяной Ксенией Бородиной шокировало всех
Интернет буквально сходит с ума из-за очень скандального видео, на котором запечатлена известная телеведущая Ксения Бородина, а также несколько ее бли...

Светикова беременна от известного фигуриста
Прославленная выпускница телепроекта "Фабрика звезд" Светлана Светикова наконец-то устроила свою личную жизнь на должном уровне...

Лазарев снимет в своем клипе экс-солистку "ВИА-Гры"
Известный певец Сергей Лазарев, только что представивший восторженной публике шоу LAZAREV в "Олимпийском", запланировал гастрольный тур по российски...

Какие женщины чаще набирают вес
Ученые австралийского Центра медицинской экономики при университете Монаш считают, что набор избыточного веса у женщин связан, как правило, с нездоров...